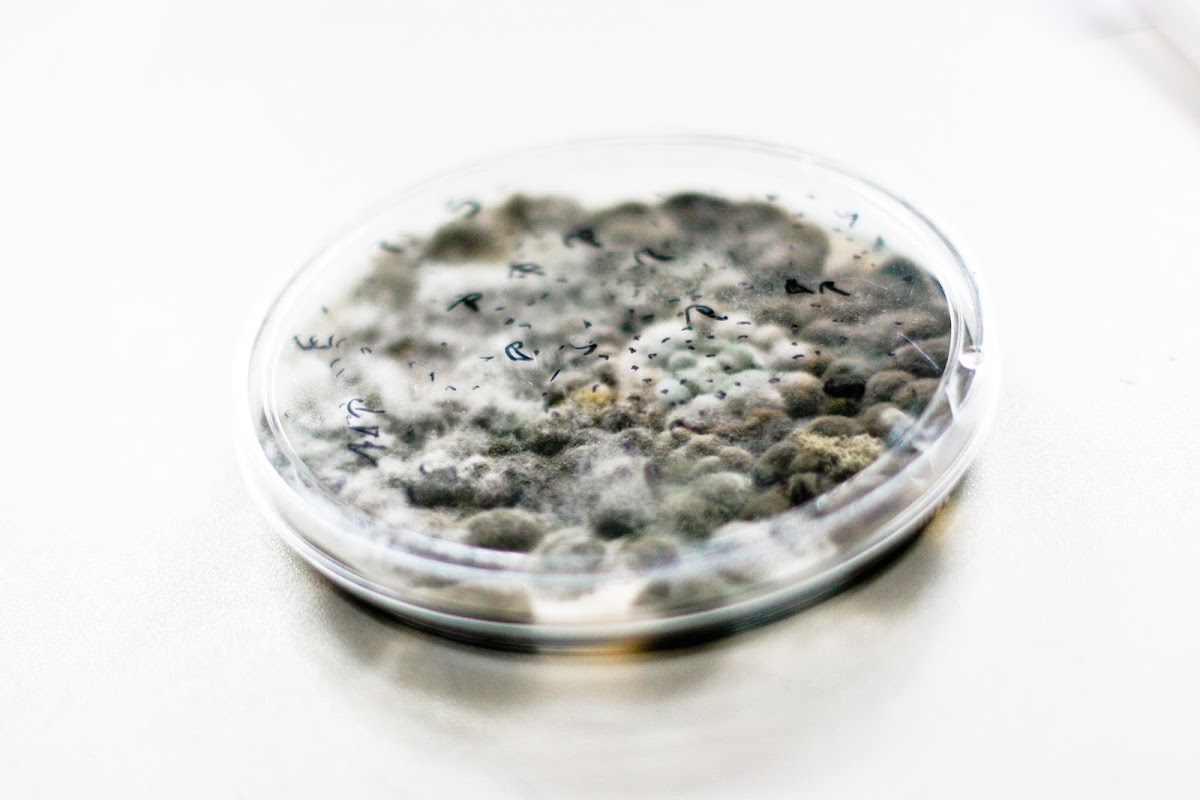
6832bc4309aa1

Bilder
(9)

Bewertungen
Noch keine Bewertungen vorhanden.
Seien Sie der Erste, der dieses Unternehmen bewertet!
